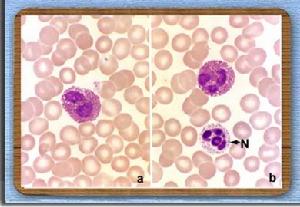
巨乳頭性結膜炎

病因
多與配戴親水性接觸鏡、硬性透氣性接觸鏡、青光眼濾泡、暴露的角膜縫線、義眼、鞏膜扣帶突出和帶狀角膜病變有關。終止戴鏡和經過藥物治療後可以痊癒。
發病機制
 巨乳頭性結膜炎
巨乳頭性結膜炎接觸鏡表面的沉積物也可造成眼瞼的創傷。Fowler等發現由GPC患者配戴接觸鏡的沉積物超過接觸鏡表面積的90%,而無症狀患者僅為5%。特別是軟性接觸鏡,可以集聚甚至專業技術人員也不能清潔的沉積物。這些沉積物包括:黏液、細胞碎屑和細菌等。使用去除蛋白製劑清潔鏡片後,患者的症狀可以消失並長達2個月。使用酶製劑(如木瓜蛋白酶)去除蛋白後可以增加對鏡片的耐受性。另外鏡片材料的透氣性也可以影響GPC的發生率。
最近其他研究結果提示瞼板腺炎和瞼板腺功能低下與GPC也存在著一定的關聯性。一種可能性是瞼板腺功能障礙及其所造成的淚膜不穩定和眼乾燥共同促使了鏡片對結膜造成的機械性外傷有證據表明GPC患者淚液的乳鐵蛋白濃度下降。這種下降可能促使了大量的細菌及其產物在鏡片的沉積同時也促進了感染的發生特別是葡萄球菌的感染。
2.Ⅰ型超敏反應 Ⅰ型超敏反應在GPC的發病過程中可能起著一定的作用。有人發現在特應性和GPC之間存在著密切的關聯性。
和其他形式的變應性結膜炎一樣已證實在GPC患者的上皮層存在有肥大細胞。在組織學上所觀察到大部分肥大細胞處於脫顆粒狀態。Henriquez等發現GPC患者結膜中30%的肥大細胞處於脫顆粒狀態,而在VKC則有80%。淚液中游離IgE水平的升高也提示發生了Ⅰ型超敏反應因為肥大細胞脫顆粒是由IgE的交聯所觸發的與之相一致的現象是細胞浸潤的類型。浸潤的細胞有嗜酸性粒細胞、嗜鹼性粒細胞和嗜中性粒細胞。這些細胞是受肥大細胞釋放的炎症介質以及後來釋放的炎症性細胞因子所吸引。由肥大細胞所釋放的血管活性物質和化學物質包括:組胺5-羥色胺、白三烯前列腺素、類胰蛋白酶糜蛋白酶組織蛋白酶G、PAF、嗜酸性粒細胞和嗜中性粒細胞趨化因子等。
3.遲髮型超敏反應 Metz等發現在GPC和VKC結膜中存在有顯著的CD4+ T淋巴細胞浸潤,且這些細胞具有記憶T細胞(CD45RO+ )的特徵。HLA-DR陽性提示這些細胞處於活化狀態。巨噬細胞數量的增加也提示局部存在抗原遞呈過程。
嗜酸性粒細胞
嗜酸性粒細胞在GPC患者的活檢標本中可以觀察到許多嗜中性粒細胞。GPC淚液中中性粒細胞趨化因子(neutrophil chemotactic factorNCF)的濃度是正常淚液的15倍。這些NCF可能是由損傷的結膜上皮細胞所分泌。NCF的出現提示了創傷與GPC之間的關係。接觸鏡配戴者但未發生GPC的患者,其淚液的NCF濃度僅是正常水平的3倍。上述現象提示單純的物理創傷在GPC發病過程的早期起著一定的作用。結膜的杯狀細胞和非杯狀上皮細胞可以產生GPC特徵性的黏厚絲狀分泌物。
5.結膜的免疫組織化學 對取自未經治療嚴重期GPC患者的瞼結膜和球結膜所進行的免疫組織化學研究顯示,在病變組織記憶體在多種炎性細胞浸潤,主要包括肥大細胞、嗜酸性粒細胞、嗜中性粒細胞、巨噬細胞和CD4+ T細胞。其數量增高提示發生了Ⅰ型和Ⅳ型超敏反應。而在相應的VKC患者,其浸潤細胞模式與GPC相似,但嗜中性粒細胞浸潤較重,而CD4+ T細胞數量較少。
6.黏附分子 和其他形式的變應性結膜炎一樣血管內皮細胞黏附分子對於GPC發病過程中組織的細胞浸潤可能起著重要的作用。許多細胞因子(IL-1、IL-4、TNF-α和IFN-γ)可以誘導血管內皮細胞表達免疫球蛋白樣分子細胞間黏附分子-1(intercellular adhesion molecule-1ICAM-1)、血管細胞黏附分子-1(vascular cell adhesion molecule-1,VCAM-1)、E-選擇素以及其他或上調其ICAM-1的基礎表達。這些分子可以俘獲在血管流動過程中攜帶相應配體的循環性白細胞,然後協助穿過細胞壁發生外滲在GPC患者中ICAM-1和E-選擇素表達升高。而在GPC瞼板組織中僅有少量的血管表達VCAM-1。
7.免疫球蛋白 在猴眼建立GPC模型,發現淚液中IgA、IgM和IgE升高。在結膜基質中發現有漿細胞、淋巴細胞和肥大細胞。對正常人所進行的研究表明,配戴硬性接觸鏡者淚液的免疫球蛋白水平高於配戴軟性接觸鏡者。其原因可能與配戴硬性接觸鏡者角膜敏感性的下降程度較重有關有關GPC患者淚液的變化,各家報導尚不一致。
8.均衡理論 非特應性患者單純的角膜沉積物或隆起的過濾泡都可以引起嚴重局灶性GPC。上述例證提示在接觸鏡、眼假體或縫線上並不存在某一特異性的抗原而是單純的機械性損傷。機械性刺激後肥大細胞脫顆粒的顯著徵象是發生風團反應。數種不同的機制都可伴有肥大細胞脫顆粒發生,包括反向神經刺激人類皮膚的肥大細胞針對P物質、VIP、生長抑素嗎啡和補體過敏毒素C3a和C5a刺激,以及膜IgE的交聯都可以發生脫顆粒肥大細胞可以產生和儲存IL-4。IL-4可以誘導T輔助細胞,特別是Th2型細胞,因此,間接導致了促使發生變應性反應的細胞因子的產生包括IL-4和IL-5。
與VKC相比,GPC有較輕程度的嗜酸性粒細胞浸潤這可能與T輔助細胞的類型以及特應性表型有關嗜酸性粒細胞需要接受產生IL-5的Th2型CD4+T細胞的影響。在非特應性個體,Th1和Th2型細胞之間產生某種相互抑制作用。但在特應性個體,則存在Th2型細胞的正反饋,從而導致某種細胞因子產生模式的放大,以活化和吸引嗜酸性粒細胞為特徵。在非特應性個體肥大細胞的脫顆粒可能是同一通路的第一步。對接觸鏡或眼假體配戴者的長期機械性刺激將導致慢性肥大細胞脫顆粒。如果肥大細胞仍處於炎症過程的第一步,那么細胞浸潤及其臨床特徵將非常近似花粉症性變應性結膜炎。一旦T淋巴細胞和嗜酸性粒細胞參與,其特徵將類似於VKC。
9.其他理論 對GPC患者,逆向刺激無髓鞘神經纖維將導致肥大細胞脫顆粒。因此造成了較大面積的炎症受累區。這可以解釋縫線造成GPC的機制。色甘酸鈉可以阻斷由辣椒素觸發的初級傳入末梢的放射性刺激。P物質可以引起小鼠肥大細胞脫顆粒,從而導致繼發性粒細胞浸潤組織水腫和血管滲透性增加。
臨床表現
 巨乳頭性結膜炎的黏性分泌物
巨乳頭性結膜炎的黏性分泌物GPC進展比較緩慢。早期主要表現為上瞼結膜輕度充血和增厚。隨著疾病的進展,炎細胞浸潤增加,結膜開始明顯增厚和混濁疾病早期的分泌物為細絲狀。隨著疾病的進一步加重出現白色黏液性分泌物通常位於下穹隆。連續配戴接觸鏡或與刺激物相接觸,將導致結膜的進一步充血和炎症反應。瞼結膜將出現乳頭並逐漸增大在正常生理狀態下,乳頭的直徑小於0.3mm。巨乳頭性結膜炎的乳頭直徑大於0.3mm。當乳頭直徑大於1.0mm時即稱為巨乳頭。
有關乳頭的外觀和位置存在著較大的變異性。A1lansmith將上瞼結膜分為3個區:1區為瞼板上緣附近的結膜;3區為靠近瞼緣的區域;介於兩者之間的為2區。軟接觸鏡相關性巨乳頭結膜炎的乳頭首先出現在1區,然後進展到2區和3區。而硬性透氣接觸鏡相關性巨乳頭結膜炎的乳頭首先出現在3區,然後進展到2區和1區。因暴露縫線帶狀角膜變性和青光眼濾過泡而發生的GPC其特徵為在刺激區出現較大的簇狀巨大乳頭。這些體徵提示慢性機械性刺激是這些病例發生巨乳頭性結膜炎的重要誘發因素。
Allansmith根據GPC的臨床表現將其分為4期:
Ⅰ期:在早晨有少量黏液性分泌物,取出鏡片時有癢感;鏡片表面偶有沉積物;瞼結膜外觀正常,可伴有輕、中度充血。
Ⅱ期:黏液性分泌物和瘙癢感加重對接觸鏡的感覺增加;鏡片表面有沉積物;視力輕度下降;常在戴鏡後幾個小時即出現症狀,患者戴鏡能力下降或受到限制。裂隙燈檢查見上瞼結膜輕度充血、增厚,瞼結膜可見大小不一的乳頭,直徑多在0.3mm以上,相鄰的幾個乳頭可以融合由於組織增厚而隆起,螢光染色後更清楚。
Ⅲ期:黏液性分泌物和瘙癢感明顯加重,鏡片表面經常有沉積物,很難保持鏡片清潔;每次瞬目均有接觸鏡存在的感覺,鏡片移位過度,導致波動性視物模糊;戴鏡時間明顯減少;上瞼結膜明顯充血和增厚,血管模糊不清,乳頭大小和數目增加,乳頭隆起。由於結膜下形成瘢痕,乳頭頂部呈白色,螢光素著色。
Ⅳ期:患者完全不能忍受戴鏡戴鏡後很短時間就感覺不適;鏡片表面很快形成沉積物和污濁鏡片移位很大,黏液性分泌物相當多嚴重者在早晨眼瞼黏在一起,上瞼結膜乳頭進一步增大,直徑多大於1mm,乳頭頂端扁平螢光素著色
GPC的臨床分型表明了病變的進展過程,但不同個體也常有一定的差異。一些患者雖然只有早期的上瞼結膜改變但有嚴重的自覺症狀;而另外一些患者無自覺症狀,但上瞼結膜卻有明顯的炎症和乳頭增生。
季節性變態反應是軟性接觸鏡患者的一個危險因素,GPC患者對接觸鏡保存液、藥物真菌、花粉和動物過敏的發生率高於無GPC接觸鏡配戴者。
診斷
 角膜接觸鏡
角膜接觸鏡鑑別診斷
GPC必須與VKC相鑑別。兩種疾病在外觀形態上常難以區分。但VKC大多發生於青春期的兒童多在20歲消失,是一種非常嚴重的疾病,與戴接觸鏡無關GPC一般與戴接觸鏡有關,不伴隨角膜潰瘍和角膜混濁。VKC患者結膜刮片一般有嗜酸性粒細胞存在,而GPC患者的存在率僅占25%。同樣,VKC患者有嗜酸性顆粒,而GPC患者則不存在。VKC患者淚液的組胺水平顯著升高,而GPC患者則無明顯升高。
偶爾細菌性結膜炎也與GPC症狀相似但細菌性結膜炎的分泌物多為膿性,呈白色黏稠性。少數衣原體、腺病毒和原發性皰疹性結膜炎的濾泡與GPC的巨大乳頭相混淆可借接觸鏡或其他眼假體配戴史相鑑別。
檢查
結膜囊分泌物細胞學檢查可發現與過敏因素有關的嗜酸性粒細胞增多。
其它輔助檢查
巨大的乳頭被覆以增厚的、不規則且有許多隱窩的結膜上皮細胞在許多病例可以觀察到表層上皮糜爛和相應的螢光素染色。電鏡下,可見上皮細胞大小各異失去正常的多角形態。其表面的微絨毛呈扁平、簇狀和分枝狀。巨乳頭性結膜炎的黏液分泌增加與乳頭表面杯狀細胞密度的增加無關,而與覆蓋乳頭表面的結膜表面積的增大有關。在乳頭間的隱窩內常含有大量的非杯狀細胞的黏液分泌細胞。這些細胞的分泌泡明顯增加。巨乳頭性結膜炎的典型特徵是結膜實質層發生嗜酸性粒細胞肥大細胞、嗜鹼性粒細胞、淋巴細胞和漿細胞浸潤。但是,在結膜上皮層內並不常見嗜酸性粒細胞、肥大細胞和嗜鹼性粒細胞 。
治療
有關GPC的治療原則如下:①減少接觸鏡表面沉積物形成。②減少戴鏡時間。③選擇大小和類型合適的接觸鏡。④藥物治療。
1.減少沉積 應使用表面活性劑對接觸鏡作定期的清潔通常1次/d。在無菌未含防腐劑的鹽水內作充分的清潔,然後放置於無菌系統內。另外,應由技術員使用酶製劑對其沉澱的蛋白做清潔工作
對於義眼之類的假體,應每天使用簡單的家用去污劑(如肥皂和兒童洗髮劑)給予清潔。在無菌鹽水和冷開水中做充分洗滌,然後乾燥儲存。有條件者,也可以使用接觸鏡的清潔液給予清潔。衛生習慣是防止GPC發生的重要因素。
2.減少接觸時間 GPC的症狀通常屬於時間依賴性,即結膜表面與異物接觸的時間越長其症狀就越嚴重。因此對於大多數接觸鏡配戴者,可以減少白天的戴鏡時間對於因社交或體育活動而配戴接觸鏡者,也應鼓勵儘量減少在各種場合的配戴時間。對於配戴諸如義眼者,不要單純從美容角度考慮問題,應該要求患者在晚間取出。
3.接觸鏡的配戴及其型別的最佳化 配戴不合適的接觸鏡可以引起或促進GPC的發生。對於鏡片的外形要給予適宜的關注,特別是鏡片的邊緣邊緣過度翹起的鏡片易造成上瞼結膜的創傷與小直徑鏡片相比,較大直徑的鏡片也易造成上述狀態。更換不同材料和設計的其他產品,如硬性透氣接觸鏡一次性接觸鏡和低含水量的甲基丙烯酸甲酯鏡片等,也有助於疾病的改善。
4.藥物治療 對於輕度和中度的病例,可以使用4%的色甘酸鈉滴眼液治療。對於重度晚期病例色甘酸鈉並無顯著療效。色甘酸鈉可以抑制嗜中性粒細胞、嗜酸性粒細胞和巨噬細胞的活化。新型藥物奈多羅米也可以減輕瘙癢感和減少黏液的分泌。奈多羅米也具有阻止炎性介質釋放和炎症細胞活化的作用。洛多醯胺(iodoxmide)是另一類肥大細胞穩定劑在活體與色甘酸鈉具有同樣的效果,但起效快。非甾體類抗炎藥如舒洛芬(噻丙吩)對於GPC的治療具有一定的益處其主要作用是抑制前列腺素合成。
局部使用糖皮質激素對於治療GPC有一定的療效。其主要作用是減輕眼瞼的充血和炎症,對於GPC的其他環節並無特殊的治療作用。一般僅限於急性期套用長期套用可引起許多潛在的併發症,如青光眼、白內障和誘發感染等,所以一般禁忌使用。而對於因配戴義眼之類物品而誘發的GPC,因不涉及對視力的損傷問題所以在必要的情況下可以局部使用。
預後
GPC預後良好一般不發生永久性視力損害。其結局是乳頭變扁平、上皮下纖維化和症狀消失。所有患者在停止配戴接觸鏡後都會得到改善。輕度的病例,僅單純通過改變鏡片的類型和設計以及清潔程式就可以得到治癒。對於嚴重的病例應停止配戴接觸鏡,並給予積極的藥物治療。
預防
選擇合適的角膜接觸鏡,並注意接觸鏡以及義眼的配戴時間,同時預防過敏性因素的作用。

